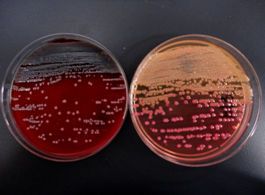

1.一般細菌培養
【①グラム染色検査】
提出された検体を直接スライドグラスに塗布し、グラム染色という細菌を染め分ける方法で菌を染色します。
【②同定・感受性検査】
提出された検体を細菌が発育するのに必要な栄養素を含んだ寒天培地に接種し、一晩培養します。 1~2日培養すると培地上にコロニーとなって発育します。 熟練した技師は発育してきた培地の種類、コロニーの色、形、 質感さらには臭いによってある程度菌を推定することができます。 菌名を確定するには、自動同定感受性測定器にかけて、菌名およびその菌に効く薬剤を調べる検査にかけます。